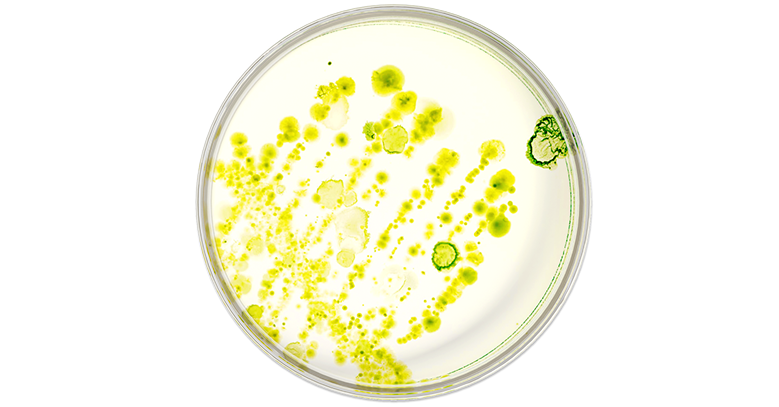
image

- die Verdauung durch weniger Blähungen und Krämpfe
- die Immunfunktion – rund 70 % der Immunzellen sitzen im Darm
- mentales Wohlbefinden über die Darm-Hirn-Achse
- Energie und Stoffwechsel durch effiziente Nahrungsverwertung
- Entzündungsregulation durch Reduktion schädlicher Bakterien

Ein zentraler Indikator für Darmgesundheit, Anpassung und Resilienz. In der Placebogruppe blieb dieser Effekt aus.

Höhere SCFAs-Werte zeigen ein gesünderes, ausgewogeneres Mikrobiom – und tragen zu langfristiger Verdauungs- und Immunstärke bei.

Diese Bakterien stehen für eine gesunde Verdauung, eine stabile Darmbarriere und geringere Entzündungsprozesse und tragen zu einem ausgewogenen, widerstandsfähigen Mikrobiom bei.

Die Stuhlfrequenz stieg über 12 Wochen leicht an und blieb im gesunden Bereich (Typ 3–4 der Bristol-Skala).
Dies weist auf verbesserte Darmpassage und stabileren Verdauungsrhythmus hin.

Bis Woche 12 und im Follow-up zeigten sich deutliche Fortschritte bei Blähungen, Bauchschmerzen, Gasbildung und Stuhlmuster.


Stress, Ernährung und Medikamente können dieses Gleichgewicht stören.
Die Wiederherstellung der mikrobiellen Vielfalt ist ein zentraler Schritt zu langfristiger Gesundheit und Resilienz.
ProbaTech™ wurde entwickelt, um es gezielt wiederherzustellen.
Darum ist ProbaTech™ nicht nur für Darmprodukte gedacht. Es steckt in ausgewählten Nupure-Formulierungen, die verschiedene Gesundheitsbereiche unterstützen – von mikrobieller Balance bis Frauengesundheit.
In jedem dieser Produkte wird der klinisch getestete ProbaTech™-Mix durch sorgfältig gewählte Zusatzstämme ergänzt, die den Produktzweck gezielt unterstützen und das Mikrobiom stärken.
























